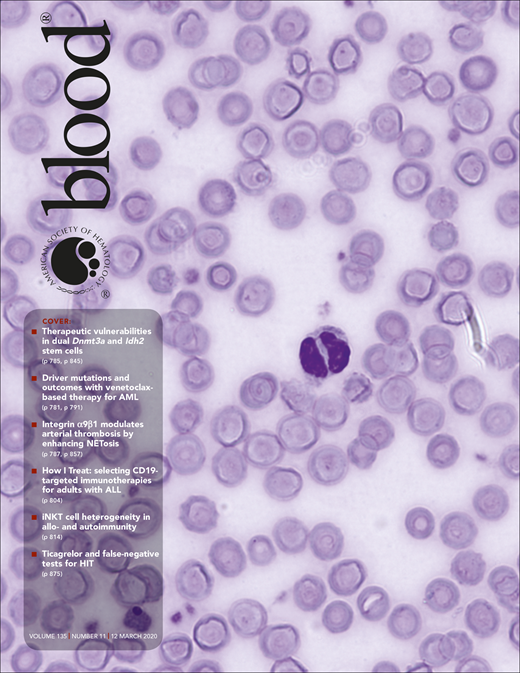
Blood Cover Image for Volume 135, Issue 11

Key Points
Nivolumab, as a monotherapy, led to complete responses in 5 of 7 r/r EBV-HLH patients and cleared EBV in 4 of them.
Nivolumab restored an anti-EBV program in CD8 T cells, as revealed by single-cell RNA-sequencing analysis.
Abstract
Epstein-Barr virus (EBV)-associated hemophagocytic lymphohistiocytosis (EBV-HLH) is a life-threatening hyperinflammatory syndrome triggered by EBV infection. It often becomes relapsed or refractory (r/r), given that etoposide-based regimens cannot effectively clear the virus. r/r EBV-HLH is invariably lethal in adults without allogeneic hematopoietic stem cell transplantation. Here, we performed a retrospective analysis of 7 r/r EBV-HLH patients who were treated with nivolumab on a compassionate-use basis at West China Hospital. All 7 patients tolerated the treatment and 6 responded to it. Five of them achieved and remained in clinical complete remission with a median follow-up of 16 months (range, 11.4-18.9 months). Importantly, both plasma and cellular EBV-DNAs were completely eradicated in 4 patients. Single-cell RNA-sequencing analysis showed that HLH syndrome was associated with hyperactive monocytes/macrophages and ineffective CD8 T cells with a defective activation program. Nivolumab treatment expanded programmed death protein-1–positive T cells and restored the expression of HLH-associated degranulation and costimulatory genes in CD8 T cells. Our data suggest that nivolumab, as a monotherapy, provides a potential cure for r/r EBV-HLH, most likely by restoring a defective anti-EBV response.
Introduction
Hemophagocytic lymphohistiocytosis (HLH) is a fatal hyperinflammatory syndrome induced by inappropriate prolonged activation of lymphocytes and macrophages.1 There are 2 categories of HLH: familial (FHL) and secondary (sHLH). FHL, caused by genetic mutations impairing the function of cytotoxic lymphocytes and natural killer (NK) cells, typically presents in infancy and early childhood. sHLH, triggered by infections, neoplasms, and autoimmune diseases, is more common in adolescence and adulthood.2 Epstein-Barr virus (EBV)-associated HLH (EBV-HLH) is 1 of the most common subtypes of sHLH and usually exhibits a poor prognosis and unsatisfactory treatment outcomes.3
To date, there is no standard treatment of EBV-HLH in adults. The most commonly used HLH-94/044,5 regimens, composed of etoposide and dexamethasone, can lead to early remission,6,7 but often end with rapid relapses.8 The central dilemma for EBV-HLH treatment is that chemotherapies that aim to eliminate the hyperactive immune cells responsible for the clinical phenotype also impair the ability of patients' immune systems to clear the underlying EBV infection which drives the disease. Current antiviral agents demonstrate marginal anti-EBV utility, which leaves allogeneic hematopoietic stem cell transplantation (allo-HSCT) as, thus far, the only potentially curative option for relapsed/refractory (r/r) EBV-HLH.9 However, the clinical usefulness of allo-HSCT is limited by the availability of matched donors, together with toxicities that negatively impact patients’ survival and quality of life. Thus, better curative therapeutic strategies are on demand for r/r EBV-HLH.
The expression levels of programmed death protein-1 (PD-1) increase on the surface of CD8 T cells following infection with EBV or other viruses.10,11 PD-1 inhibitors, approved for multiple cancers, have been shown to be effective for chronic viral infections in animal models12 and, recently, for progressive multifocal leukoencephalopathy associated with JC virus.13 Interestingly, these antibodies also achieve high response rates in EBV+ gastric cancer14 and NK/T lymphoma.15 A possible explanation is that PD-1 blockade reverses EBV/cancer-related immunosuppression, thereby restoring the immunity required to restrain cancer cells and also to clear EBV infection. However, it has not previously been investigated whether PD-1 antibodies would be safe and effective for r/r EBV-HLH, a hyperinflammatory syndrome.
Methods
Patients
We retrospectively analyzed the clinical data from 7 r/r EBV-HLH patients treated with nivolumab as compassionate use at West China Hospital (ChiCTR 1900026232). All 7 patients provided written informed consent to receive off-label treatment with nivolumab and for blood sample collection. HLH was diagnosed according to the HLH-2004 diagnosis guidelines.5 EBV-HLH was diagnosed using DNA polymerase chain reaction (PCR) testing with a threshold of 103 EBV-DNA copies per milliliter in plasma for confirmation of EBV infection.1 Fluorodeoxyglucose–positron emission tomography/computed tomography and bone marrow smear were performed to exclude malignancy-associated HLH. A panel of 26 HLH-related genes was analyzed by next-generation sequencing to exclude FHL (supplemental Table 1, available on the Blood Web site). r/r EBV-HLH was defined as persistent, recurrent, or worsening symptoms after at least 6 weeks of etoposide- and dexamethasone-based chemotherapies. As primary EBV infection had a feature of self-limitation, at least 3 months had to elapse between the estimated onset of symptoms and commencement of nivolumab administration. Patients aged 15 years or older with r/r EBV-HLH and without available HLA-matched donors were included. This study was approved by the ethics committee of West China Hospital of Sichuan University [HX-2019-(709)].
Treatment
Patients received nivolumab, as a monotherapy, at a dose of 100 to 200 mg via IV infusion every 3 to 4 weeks for induction therapy. Treatment was stopped if grade 3 or higher immune-related adverse events occurred or the disease continued to progress after 4 cycles of nivolumab infusions. When plasma EBV-DNA became undetectable, nivolumab was administrated at 100 mg every 3 months as maintenance therapy for up to 1 year.
Clinical and laboratory evaluations were performed weekly during induction therapy and before each infusion; evaluations included performance status, vital signs, plasma EBV-DNA copy number, size of spleen and liver, complete blood count and levels of alanine aminotransferase (ALT), triglyceride, fibrinogen, lactate dehydrogenase, soluble CD25 (sCD25), and ferritin. Intracellular EBV-DNA copy number was quantified by quantitative PCR in sorted B, T, and NK cells.
Assessment of response
Therapeutic response was assessed in accordance with established criteria as previously described.3,16 Complete response (CR) was defined as the resolution of all clinical signs and symptoms (clinical CR) and normalization of all abnormal laboratory parameters including undetectable EBV-DNA in plasma (molecular CR). Partial response was defined as a minimal 25% improvement in ≥2 quantifiable symptoms and laboratory parameters, including >25% decrease in plasma EBV-DNA copy number; >1.5-fold decrease in sCD25 levels; >25% decrease in serum ferritin and triglyceride levels; >100% increase in the blood neutrophil count (to >0.5 × 109/L if the initial count was <0.5 × 109/L or >2.0 × 109/L if the initial count was 0.5-2.0 × 109/L); and >50% decrease in serum ALT levels in patients with liver dysfunction. Failure to achieve CR or partial response was defined as no response.
Single-cell RNA-sequencing analysis
Single-cell RNA-sequencing (scRNA-seq) was performed on peripheral blood cells from patient 7 before (day 0, T0), during nivolumab treatment (day 7, T1; day 21, T2), and when plasma EBV became negative (day 76, T3). scRNA-seq libraries were generated following the recommended protocol of the 3′ scRNA-seq 10× genomics platform and using v2 chemistry by the manufacturer, and sequencing data were collected with Illumina NovaSeq 6000. Cellranger (version 3.0.0) was used for alignment to human genome hg19. The Seurat workflow was applied to classify cell subtypes and T-distributed stochastic neighbor embedding was used to reduce dimensions.17 Single-cell data of individual subgroups were integrated to mimic bulk RNA sequencing files by calculating the mean value of each gene expression, visualized by heatmap. Kyoto Encyclopedia of Genes and Genomes (KEGG) pathways in CD8 T cells of different time points, enriched by ClusterProfiler, and gene networks were visualized by the cnetplot.enrichResult formula.18
Results
Patient characteristics
A total of 7 patients with r/r EBV-HLH were enrolled in the study, with a median age of 25 years (range, 15-36 years) and comprising 4 males and 3 females (Table 1). All patients presented with typical features of aggressive HLH signs, including persistent high fever, life-threatening cytopenia, and high levels of serum ferritin and sCD25. Their plasma EBV-DNA loads were >104 copies per milliliter (range, 3.99 × 104/mL to 2.10 × 107/mL). Malignancies were excluded by fluorodeoxyglucose–positron emission tomography/computed tomography and/or bone marrow smear. Genetic testing showed that, except for heterozygous mutations in the UNC13D gene in 2 patients (patients 2 and 3), no HLH-related genetic mutations were detected. Although it has been reported that heterozygous UNC13D or other HLH-related mutations can contribute to late-onset HLH,19-21 neither of their parents with the same mutations were symptomatic.
The median duration of primary chemotherapy was 19.6 weeks (range, 6.3-72 weeks), after which 2 patients did not respond to the chemotherapy, while 5 patients experienced transient ameliorations followed by rapid relapses (supplemental Table 2). The clinical course, from the estimated onset of HLH symptoms to the first nivolumab infusion, was >3 months for all patients.
Efficacy
Six of seven patients responded to nivolumab (patients 1-4, 6, and 7). Five of them (patients 1-4 and 7) achieved a clinical CR while another (patient 6) responded only transiently (supplemental Figure 1A). One patient (patient 5) had no response to the treatment with persistent fever and a high plasma EBV-DNA copy number (supplemental Figure 1B). Four of the 5 patients who achieved a clinical CR also achieved a molecular CR. All 5 clinical CR patients have remained in remission for >40 weeks within a median follow-up of 16 months (range, 11.4−18.9 months) (Figure 1; supplemental Table 3).
Swimmer plot of time on treatment of 7 r/r EBV-HLH patients. Dashed lines indicate the end of induction and start of maintenance treatment; solid lines indicate the cessations of nivolumab treatment. CsA, cyclosporin A; ED, etoposide plus dexamethasone; GED, gemcitabine plus etoposide plus dexamethasone; l-Asp, l-asparaginase.
Swimmer plot of time on treatment of 7 r/r EBV-HLH patients. Dashed lines indicate the end of induction and start of maintenance treatment; solid lines indicate the cessations of nivolumab treatment. CsA, cyclosporin A; ED, etoposide plus dexamethasone; GED, gemcitabine plus etoposide plus dexamethasone; l-Asp, l-asparaginase.
For the 5 clinical CR patients, the median time and cycles from the first nivolumab infusion to clinical stabilization were 21 days (range, 2-59 days) and 1.6 cycles (range, 1-3 cycles). Plasma EBV-DNA copy number decreased gradually in all of these patients. Four clinical CR patients reached a molecular CR after a median of 15 weeks (range, 10.7-21 weeks) and 4.5 cycles (range, 3-6 cycles) of nivolumab infusions. Patient 1, with prolonged intervals between infusions after reaching clinical CR, failed to achieve molecular CR (Figure 2A).
Dynamics of clinical and laboratory parameters after nivolumab infusions in patients with clinical CR. (A) Dynamics of body temperature (black lines) and plasma EBV-DNA copy numbers (blue lines) in clinical CR patients (n = 5) during nivolumab induction therapy. (B) White blood cell (WBC) count, platelet (PLT) count, and hemoglobin (Hb) concentration in peripheral blood of clinical CR patients. (C-D) Levels of sCD25 (C) and ferritin (D) in serum of clinical CR patients.
Dynamics of clinical and laboratory parameters after nivolumab infusions in patients with clinical CR. (A) Dynamics of body temperature (black lines) and plasma EBV-DNA copy numbers (blue lines) in clinical CR patients (n = 5) during nivolumab induction therapy. (B) White blood cell (WBC) count, platelet (PLT) count, and hemoglobin (Hb) concentration in peripheral blood of clinical CR patients. (C-D) Levels of sCD25 (C) and ferritin (D) in serum of clinical CR patients.
The hemoglobin concentration and platelet count increased in all clinical CR patients, with cytopenias resolving around 6 weeks after the first nivolumab infusions (Figure 2B). Levels of HLH markers ferritin and sCD25 decreased and reached the normal range in the 5 clinical CR patients. Intracellular EBV-DNA in sorted B, T, and NK cells was undetectable after achievement of molecular CR in the 3 patients tested (patients 3, 4, 7), as determined by quantitative PCR (data not shown).
Safety
No grade 3 or higher immune-related adverse events were recorded in any of the patients. During induction, persistent or slightly elevated fever was observed in the 4 of the 5 responding patients, lasting for ∼1 to 2 weeks (Figure 2A). Transient worsening of cytopenias and increase in the level of serum ferritin or sCD25 were also detected in 4 patients. However, plasma EBV load decreased simultaneously in all of these patients, suggesting that these pseudoprogressions might be due to the enhancement of ongoing anti-EBV immunity. Finally, all clinical symptoms resolved and laboratory parameters became normal without any additional HLH-related treatment. Patient 6 experienced EBV reactivation after 2 nivolumab infusions and discontinued the therapy.
During maintenance therapy, patient 3 had transient and mild skin pruritus and depigmentation after 5 cycles of nivolumab. Otherwise, no treatment-related adverse events were observed.
scRNA-seq analysis
To explore the molecular and cellular mechanisms of nivolumab treatment of r/r EBV-HLH, scRNA-seq was performed with peripheral blood cells of patient 7 before (T0, day 0), 1 week after treatment (T1, day 7), after clinical CR (T2, day 21) and when plasma EBV-DNA became negative (T3, day 76). Cell types were identified according to their expression of marker genes (supplemental Figure 2).
Hyperactive monocytes/macrophages have been proposed to be major effector cells in HLH.22 Our scRNA-seq analysis showed that >25% of monocytes/macrophages at T0 expressed abnormally high levels of active markers, such as TNF, IL1B, and CD163. The expression levels of these genes and also the proportion of this activated monocyte/macrophage population were dramatically decreased at T1 and thereafter (supplemental Figure 3). In addition, there was a large population of abnormal CD8 T cells, indicated by high expression levels of IFNG and GZMB, at T0 and this cell population gradually reduced from T1 to T3 (Figure 3A). Interestingly, these cells also expressed high levels of PDCD1 (gene that encodes PD-1) and LAG3, markers of T cell exhaustion (Figure 3A-B; supplemental Figure 4). Notably, PD-1+ T cells expanded rapidly after the first nivolumab infusion, with high expression of MKI67, implying being in active cell cycle. These cytotoxic T cells continued to expand at T2 but with reduced expression of LAG3 and MKI67, correlated with a further decrease in EBV-DNA copy number. At T3, the cellular composition and the gene signature of the patient’s blood were similar to those of healthy adults,23 thereby further supporting the concept of molecular CR (supplemental Figures 2A-B and 4). Importantly, gene network analysis showed that T0 CD8 T cells highly expressed genes enriched in the EBV infection pathway, the T-cell receptor signaling pathway, and also the apoptosis pathway, consistent with the hyperinflammatory syndrome associated with the disease (Figure 3C). Surprisingly, multiple T-cell activation pathways and the degranulation pathway were positively enriched in CD8 T cells after the first nivolumab treatment (T1), compared with T0 CD8 T cells, suggesting that nivolumab restored the defective cytotoxicity of CD8 T cells (Figure 3D). Importantly, the expansion and activation of these PD-1+ CD8 T cells were correlated with a dramatic reduction in intracellular EBV-DNA copy number in B and NK cells, suggesting that nivolumab enhanced anti-EBV activity (Figure 3E).
scRNA-seq analysis of peripheral blood cells of patient 7 before and after nivolumab infusions. (A) Top, Violin plots showing the expressions of IFNG, GZMB, and LAG3 in CD8 T cells at different time points. Bottom, Pie charts showing the ratios of IFNG, GZMB, and LAG3 positive CD8 T cells at different time points. (B) Expression levels of PDCD1 projected on T-distributed stochastic neighbor embedding graphs of T0 and T1 peripheral blood cells. (C-D) Regulatory networks of signature genes in CD8 T cells at T0 (C) and T1 (D), analyzed with ClusterProfiler. Sizes of circles for enriched pathways indicate the numbers of genes enriched in these pathways and colors of dots for each gene indicate their relative expression levels. (E) Line chart showing intracellular EBV-DNA copy number in NK, B, and T cells. (F) Heatmap showing the expression levels of HLH-related genes in CD8 T cells. (G) Heatmaps showing the expression levels of gene ontology (GO) leukocyte degranulation genes (left) and costimulatory receptors genes (right) in CD8 T cells.
scRNA-seq analysis of peripheral blood cells of patient 7 before and after nivolumab infusions. (A) Top, Violin plots showing the expressions of IFNG, GZMB, and LAG3 in CD8 T cells at different time points. Bottom, Pie charts showing the ratios of IFNG, GZMB, and LAG3 positive CD8 T cells at different time points. (B) Expression levels of PDCD1 projected on T-distributed stochastic neighbor embedding graphs of T0 and T1 peripheral blood cells. (C-D) Regulatory networks of signature genes in CD8 T cells at T0 (C) and T1 (D), analyzed with ClusterProfiler. Sizes of circles for enriched pathways indicate the numbers of genes enriched in these pathways and colors of dots for each gene indicate their relative expression levels. (E) Line chart showing intracellular EBV-DNA copy number in NK, B, and T cells. (F) Heatmap showing the expression levels of HLH-related genes in CD8 T cells. (G) Heatmaps showing the expression levels of gene ontology (GO) leukocyte degranulation genes (left) and costimulatory receptors genes (right) in CD8 T cells.
Loss-of-function mutations of genes important for the biology of cytotoxic T and/or NK cells are known to contribute to HLH development.24 Intriguingly, our data from patient 7 showed that the expression of multiple such genes, such as STXBP2, UNC13D, SH2D1A, and CD27, in the absence of detectable mutations was repressed in CD8 T cells at T0 (Figure 3F). STXBP2 and UNC13D are involved in the cytotoxic granule-releasing pathway, whereas SH2D1A and CD27 are important for T-cell costimulation. Thus, dysregulation of these genes might underlie the defective cytotoxicity of T cells and their failure to eradicate EBV. Consistently, the expression of other critical costimulatory receptor genes and leukocyte degranulation genes, notably CD28, SLAMF1, and LYN, was also repressed in T0 CD8 T cells. The expression of these genes was upregulated in CD8 T cells at T1 and then downregulated at T2 and T3, in parallel with EBV clearance and symptom resolution (Figure 3G).
Discussion
In this retrospective study, we found that nivolumab was highly effective in both disease control and EBV eradication for patients with r/r EBV-HLH. Five of the 7 patients (71.4%) achieved a sustained clinical CR with resolution of all features of the disease without relapse during the follow-up period of up to 1.5 years. Importantly, EBV-DNA was undetectable in the plasma or lymphocytes of 4 of the 7 patients (57.1%). Remarkably, although HLH is generally thought to be a hyperinflammatory syndrome, nivolumab was well tolerated, with no drug-related severe adverse effects observed in any of the 7 patients.
The current HLH-94/04 regimens use etoposide to target activated T cells and suppress the inflammatory syndrome in EBV-HLH.25 However, these immune cells are also the major effector cells in the fight against EBV. In keeping with this dilemma, patients with EBV-HLH frequently relapse early after chemotherapy.8 Recent studies suggested that ruxolitinib and emapalumab may be effective for HLH control.26,27 However, because EBV-HLH patients were not included in these studies, their potential effects for EBV-HLH remain to be tested. Theoretically, the main effects of these agents were calming the cytokine storm while leaving the real syndrome initiator, EBV infection, untreated, so they are unlikely to be able to cure EBV-HLH. Rituximab-containing chemoimmunotherapeutic regimens have been suggested to improve clinical status in 43% of EBV-HLH cases.28 But their ability to clear EBV was limited, especially when other immune cells, such as T and NK cells, became infected. In contrast, in our study, nivolumab achieved a sustained clinical CR in 5 of 7 r/r EBV-HLH patients and, more importantly, completely eradicated EBV in all types of lymphocytes in 3 of these patients. These results strongly suggest that PD-1 inhibition would be a potential cure for r/r EBV-HLH.
It may appear paradoxical to apply nivolumab, a PD-1 inhibitor, to treat a hyperinflammatory condition such as EBV-HLH. Surprisingly, our scRNA-seq study showed that multiple HLH-related genes, such as CD27 and STXBP2, that are involved in T-cell activation failed to be upregulated in hyperactive CD8 T cells in EBV-HLH. This important observation might explain the inability of the immune system to eliminate EBV in EBV-HLH and suggests a novel mechanism responsible for disease initiation and perpetuation. Nivolumab treatment expanded a subpopulation of cytotoxic T cells with high levels of PD-1 and LAG-3. Furthermore, a large proportion of these cells became MKI67+ after the first nivolumab infusion, indicating that they were reactivated and proliferating from a previously exhausted population. Similar phenotypes have also been observed in cancer patients after PD-1 or PD-L1 (PD-1 ligand) blockades.29 Meanwhile, nivolumab restored the expression of all of the HLH-related costimulatory and degranulation genes that were previously repressed in this cell population, and this normalization of the cytotoxic activation program was correlated with EBV clearance. Interestingly, 2 patients with heterozygous mutations in the UNC13D gene also responded to nivolumab and successfully achieved a molecular CR, suggesting that the cytotoxic function of immune cells with heterozygous hypomorphic mutations of HLH-related genes can also be restored by PD-1 inhibition. It would be interesting to conduct future studies to investigate whether PD-1 inhibitors could be effective for adult-onset FHL and other sHLH.
In conclusion, our study suggests that nivolumab can achieve sustained control of r/r EBV-HLH with tolerable toxicity. Furthermore, serological and intracellular negative conversion of EBV-DNA suggests that PD-1 blockade has the potential to cure the disease without allo-HSCT. Larger systematically protocol-driven prospective clinical trials and further mechanism studies are warranted.
The scRNA-seq data reported in this article have been deposited in the Gene Expression Omnibus database (accession number GSE138504). Code used in this study is available on Github (https://github.com/pangxueyu233/Nivolumab-treatment-for-r-r-EBV-HLH). Original clinical data will be available by contacting the corresponding author T.L. (liuting@scu.ed.cn).
The online version of this article contains a data supplement.
The publication costs of this article were defrayed in part by page charge payment. Therefore, and solely to indicate this fact, this article is hereby marked “advertisement” in accordance with 18 USC section 1734.
Acknowledgments
The authors thank all of the patients and their families for participation. The authors also thank Andrew Pettitt (Department of Molecular and Clinical Cancer Medicine, University of Liverpool) and Lieven Bekaert for language revision.
This work was supported by the National Key R&D Program of China (2017YFA0505600 [Y.L. and C.C.]) and the National Natural Science Foundation of China (no. 81670182 [Y.L.] and no. 81370595 [T.L.]).
Authorship
Contribution: T.L., Y.L., and C.C. designed and supervised this study; T.N., X.S., J.L., Y.G., L.X., and Y.W. recruited and treated the patients; X.P., P.L., J.W., and X.C. performed scRNA-seq analysis; P.L., X.P., C.C., Y.L., and T.L. analyzed the data and wrote the paper; and all authors read and approved the final manuscript.
Conflict-of-interest disclosure: The authors declare no competing financial interests.
Correspondence: Ting Liu, Department of Hematology, Hematology Research Laboratory, State Key Laboratory of Biotherapy and Cancer Center, West China Hospital, Sichuan University, No. 37 Guo Xue Xiang St, Chengdu, Sichuan, China, 610041; e-mail: liuting@scu.edu.cn; and Yu Liu, Department of Hematology, Hematology Research Laboratory, State Key Laboratory of Biotherapy and Cancer Center, West China Hospital, Sichuan University, No. 37 Guo Xue Xiang St, Chengdu, Sichuan, China, 610041; e-mail: yuliuscu@scu.edu.cn.
REFERENCES
Author notes
P.L. and X.P. contributed equally to the article.